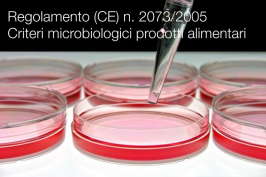
Regolamento (CE) n. 2073/2005

Regolamento (CE) n. 2073/2005
Regolamento (CE) n. 2073/2005 / Criteri microbiologici prodotti alimentari
Regolamento (CE) n. 2073/2005 della Commissione del 15 novembre 2005 sui criteri microbiologici applicabili ai prodotti alimentari
(GU L 338/1 del 22.12.2005)
_______…
UNI/PdRxx:2019 | Linee guida prodotti alimentari e bevande senza additivi

UNI/PdRxx:2019 | Linee guida per prodotti alimentari e bevande senza additivi
UNI, 01 Marzo 2019
Approvato il progetto di prassi di riferimento UNI dal titolo “Linee guida per prodotti alimentari e…
Leggi tutto UNI/PdRxx:2019 | Linee guida prodotti alimentari e bevande senza additiviGuida nuove etichette prodotti della pesca destinate ai consumatori EU

Guida sulle nuove etichette dell’UE per i prodotti della pesca e dell’acquacoltura destinate ai consumatori
Dal 13 dicembre 2014 sono cambiate le norme per le etichette destinate ai consumatori che accompagnano tutti…
Legge 3 febbraio 2011 n. 4

Legge 3 febbraio 2011 n. 4
Disposizioni in materia di etichettatura e di qualità dei prodotti alimentari.
(GU Serie Generale n.41 del 19-02-2011)
Entrata in vigore del provvedimento: 06/03/2011
...
Modifiche:
DECRETO-LEGGE…
Leggi tutto Legge 3 febbraio 2011 n. 4Direttiva 84/500/CEE
Direttiva 84/500/CEE
Direttiva 84/500/CEE del Consiglio del 15 ottobre 1984 relativa al ravvicinamento delle legislazioni degli Stati Membri per quanto riguarda gli oggetti di ceramica destinati ad entrare in contatto con…
Leggi tutto Direttiva 84/500/CEEDirettiva 2002/72/CE
Direttiva 2002/72/CE
Direttiva 2002/72/CE della Commissione del 6 agosto 2002 relativa ai materiali e agli oggetti di materia plastica destinati a venire a contatto con i prodotti alimentari.
G.U L220 del 15.08.2002
Abrogata da: Regolamento (UE) n. 10/2011 della Commissione, del 14 gennaio 2011 , riguardante i materiali e gli oggetti di materia plastica destinati a venire a contatto con i prodotti alimentari Testo rilevante ai fini del SEE
Regolamento (UE) 2017/625

Regolamento (UE) 2017/625 / Consolidato 01.2025
ID 6783 | 05.04.2025 / in allegato
Regolamento (UE) 2017/625 del Parlamento europeo e del Consiglio, del 15 marzo 2017, relativo ai controlli ufficiali…
Leggi tutto Regolamento (UE) 2017/625Regolamento (CE) n. 889/2008

Regolamento (CE) n. 889/2008
Nota Min. Salute 00411148-P del 10.12.2012
Nota Min. Salute 00411148-P del 10.12.2012
Nota esplicativa. SCIA per attività di intermediazione - Linee Guida applicative del Regolamento n. 852/2004/CE del Parlamento Europeo e del Consiglio sull'igiene dei prodotti alimentari.
Min Salute 10.12.2012
Collegati
Regolamento (UE) n. 1169/2011

Regolamento (UE) n. 1169/2011 (FIAC - Fornitura Informazione sugli Alimenti al Consumatore)
ID 7883 | Update news 08.09.2023
Regolamento (UE) n. 1169/2011 del Parlamento europeo e del Consiglio del 25 ottobre 2011…
Leggi tutto Regolamento (UE) n. 1169/2011D.Lgs. 6 novembre 2007 n. 193

Decreto Legislativo 6 novembre 2007 n. 193 / Controlli in materia di sicurezza alimentare
ID 6310 | News aggiornata 11.01.2024
Attuazione della direttiva 2004/41/CErelativa ai controlli in materia di sicurezza…
Decreto 18 dicembre 2018

Decreto 18 dicembre 2018
Emanazione del nuovo tesserino elettronico di polizia giudiziaria dell'Ispettorato centrale della tutela della qualita' e della repressione delle frodi dei prodotti agroalimentari.
(GU n.2 del 03.01.2019)…
Leggi tutto Decreto 18 dicembre 2018Decreto 5 ottobre 2018
Decreto 5 ottobre 2018
Ministero delle politiche agricole alimentari, forestali e del turismo
Aggiornamento degli allegati 1, 7, 8 e 13 del decreto legislativo 29 aprile 2010, n. 75, recante: «Riordino…
Leggi tutto Decreto 5 ottobre 2018Regolamento di esecuzione (UE) 2018/1584
Regolamento di esecuzione (UE) 2018/1584
della Commissione del 22 ottobre 2018 che modifica il regolamento (CE) n. 889/2008 recante modalità di applicazione del regolamento (CE) n. 834/2007 del Consiglio relativo alla produzione biologica e all'etichettatura dei prodotti biologici, per quanto riguarda la produzione biologica, l'etichettatura e i controlli
GU L 264/1 del 23.10.2018
Entrata in vigore: 12.11.2018
_________
Collegati:
Decreto 27 novembre 2009
Decreto 27 novembre 2009
Disposizioni per l'attuazione dei regolamenti (CE) n. 834/2007, n. 889/2008 e n. 1235/2008 e successive modifiche riguardanti la produzione biologica e l'etichettatura dei prodotti biologici. (Decreto n. 18354). (10A01133)
(GU n.31 del 08-02-2010 - SO n. 24)
Note:
Decreto abrogazione e sostituito dal decreto Decreto 18 luglio 2018
Collegati
Leggi tutto Decreto 27 novembre 2009
Regolamento (CE) n. 834/2007
Regolamento (CE) n. 834/2007
GU L 189 del 20.7.2007
Collegati






































